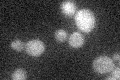
YKL135C
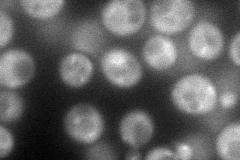
YKL135C
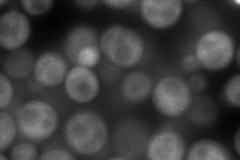
YKL135C
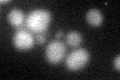
YKL135C
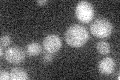
YKL135C

View description
Beta-adaptin, large subunit of the clathrin-associated protein (AP-1) complex; binds clathrin; involved in clathrin-dependent Golgi protein sorting
Localization:
Intensity:
Fold change:
Significance:
-
C’ GFP library in SD
below threshold16.06 -
N' NOP1pr-GFP in SD
cytosol,punctate93.8719 -
N' TEF2pr-mCherry in SD
cytosol103.807 -
N' NATIVEpr-GFP in SD

punctate35.5126 -
N' TEF2pr-VC and Cyto-VN in SD

cytosol30.8304 -
C’ GFP library in SD+DTT
cytosol18.371.14No -
C’ GFP library in SD+H2O2

cytosol18.621.15No -
C’ GFP library in Starvation Media
cytosol15.480.96No -
C’ GFP library on the background of Pup2-DaMP

below threshold -
C’ GFP library on the background of CCT mutant

below threshold19.95581.24252No
